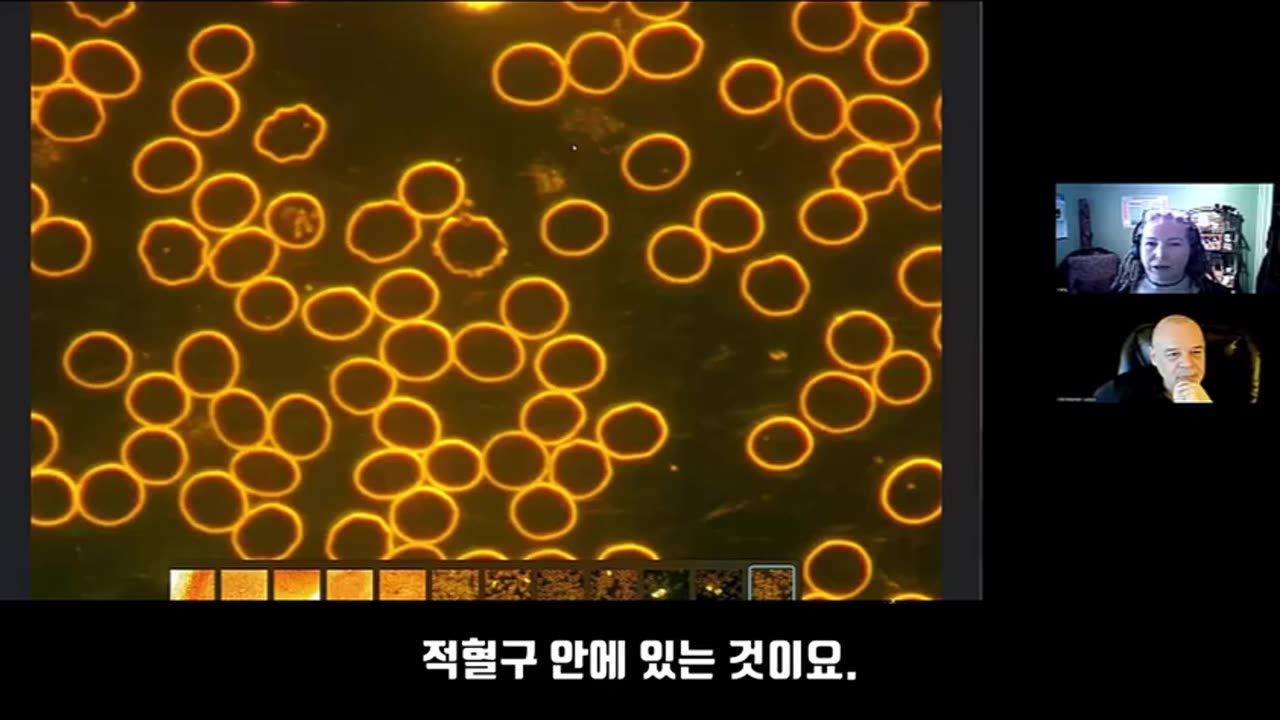

Premium Only Content
This video is only available to Rumble Premium subscribers. Subscribe to
enjoy exclusive content and ad-free viewing.
인류의 혈액 오염
Loading comments...
-
2:57:12
TimcastIRL
4 hours agoDems SHUTDOWN Government For NO KINGS Insurrection, Block Police Pay | Timcast IRL
181K47 -
LIVE
Badlands Media
10 hours agoBaseless Conspiracies Ep. 154
3,881 watching -
LIVE
Inverted World Live
4 hours agoRex Jones Calls In From The Gray Area | Ep. 122
1,827 watching -
5:56:17
Rallied
6 hours ago $0.07 earnedBF6 with THE BOYS
26.3K4 -
1:05:18
Flyover Conservatives
22 hours agoThe SEAL-Turned-CEO Paying Off Millions in Veteran Medical Debt: JOIN THE MISSION! - Bear Handlon, Born Primitive | FOC Show
25K2 -
LIVE
Drew Hernandez
8 hours agoTRUMP'S GAZA PEACE PLAN PHASE 1 & TRUMP THREATENS PUTIN WITH TOMAHAWKS
696 watching -
1:18:38
Glenn Greenwald
6 hours agoProf. John Mearsheimer on Trump's Knesset Speech, the Israel/Hamas Ceasefire, Russia and Ukraine, and More | SYSTEM UPDATE #530
98.3K58 -
2:21:37
Tucker Carlson
5 hours agoAlex Jones Warns of the Globalist Death Cult Fueling the Next Civil War and Rise of the Antichrist
70.4K328 -
12:35
Clownfish TV
13 hours agoJimmy Kimmel Return NOT Helping Disney AT ALL! DIS Stock Keeps Falling! | Clownfish TV
20K5 -
LIVE
Eternal_Spartan
7 hours ago🟢 Eternal Spartan Plays Final Fantasy 7 Rebirth Ep. 10 | USMC Vet
199 watching